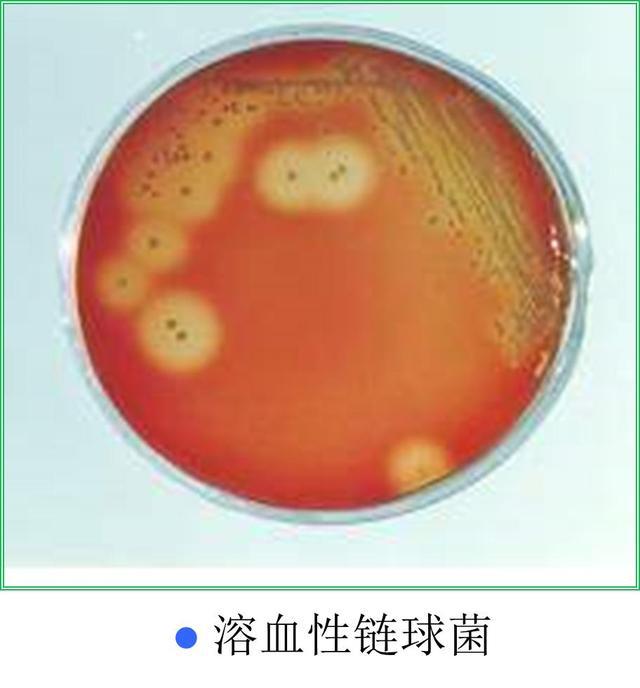

治疗皮肤软组织感染,头孢地尼针对性强
- 健康知识
- 2024-01-21
- 379
皮肤软组织感染是一种常见的皮肤病,一般临床表现为红、肿、热、痛及局部的功能障碍,严重感染时可出现全身症状,如发热、心动过速、血压下降等。引起皮肤软组织感染的主要病原菌是金黄色葡萄球菌和β溶血性链球菌,可产生脓液,如疖、痈脓肿及局限性创面脓毒症等;而进展较快的感染如丹毒、淋巴管炎及蜂窝织炎,通常由β溶血性链球菌感染所致。
疗效观察
重庆医科大学临床学院感染科曾爱中【1】等以头孢地尼和头孢特仑酯随机对照治疗急性皮肤、软组织感染,评价头孢地尼的疗效及安全性。入选的36例患者年龄18~65岁, 经症状、体征、实验室及病原学检查诊断为皮肤、软组织细菌感染(80%以上细菌阳性率),随机分为头孢地尼组和头孢特仑酯组各18例。实验组服用头孢地尼100~200mg,每日3次;对照组服用头孢特仑酯100~200mg,每日3次。两组疗程均为7~14天,用药期间每日观察患者症状、体征变化及不良反应发生情况。
结果显示,实验组的痊愈率和有效率分别为77.8%与94.4%,对照组痊愈率和有效率分别为72.7%、88.9%。两组的细菌阳性率、清除率分别为83.3%、88.9%和93.3%、87.5%。两组不良反应发生率分别为0和6.25%(P>0.05)。
另据国外文献报道,采用头孢地尼100~200mg治疗轻、中度皮肤、软组织感染临床有效率在 91%~97%之间,细菌清除率在87%~100%之间。本研究结果表明,头孢地尼的临床有效率为 94. 4%,与国外文献报道相似。
用药注意事项
头孢地尼属于第三代头孢类抗生素,其最大特点是对革兰阴性菌有强大的抗菌活性, 同时大大增加了对革兰阳性菌活性,且对大部分β-内酰胺酶稳定;另一个特点是对敏感的革兰阳性和革兰阴性菌的抗生素后效应较为明显,如金黄色葡萄球菌(0.8~1.5小时)、肺炎链球菌(0.5~1小时)、化脓链球菌(2小时)。适用于金黄色葡萄球菌和化脓性链球菌引起的皮肤和软组织的感染,包括脓疱病、脓皮病、峰窝组织炎、皮下脓肿等。【2】

1.成人口服,一次0.1g,一日3次;儿童口服,每日9~18mg/kg,分3次口服。不能擅自增加剂量或缩短用药时间间隔。
2.因食物可使头孢地尼吸收减少10~16%,影响较小,可不考虑食物影响,餐前或餐后均可服用。
3.同时服用补铁剂、多维元素、含铁量较高的食品(如奶粉),可出现红色粪便。
4.若与补铁剂、抗酸药(含铝、镁)同服,至少间隔2小时,因两类药物可降低头孢地尼的吸收。
头孢地尼(分散片商品名:达力先)对多种造成皮肤软组织感染的细菌敏感,具有疗效明确、抗菌效果良好、不良反应轻等特点,值得临床推广。
【1】曾爱中,辛小娟,肖永红,等.头孢地尼治疗36例皮肤软组织感染临床疗效及抗菌活性观察[J].重庆医科大学学报,2003,28(2):230-232.
【2】.头孢地尼的最大特点和用药交待.药评中心,2018年12月.
(原文首发于《医师在线》杂志2019年第23期)
发表评论